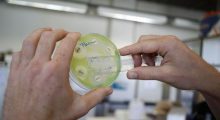

De acuerdo con el Consejo Nacional de Ciencia, Tecnología e Innovación Tecnológica (Concytec), actualmente hay 2,500 mujeres científicas a nivel nacional, pero más del 51% trabaja en Lima, mientras hay regiones, como Pasco, que apenas tienen 6 investigadoras.
The Mars Society Perú estudiará cómo crecen y se comportan dos tipos de bacterias en condiciones de microgravedad

Impartido por la Dra. Mª Victoria Fonseca, catedrática de Física Atómica, Molecular y Nuclear de la Universidad Complutense de Madrid Jornada introductoria gratuita: 21 de Febrero, a las 19:15h, en Centro Universitario Philippus Thuban (Avenida de Brasilia, 3)Algunos datos impactantes: El 95% de lo que hay en el universo es desconocido. Sólo conocemos un 5% de […]
